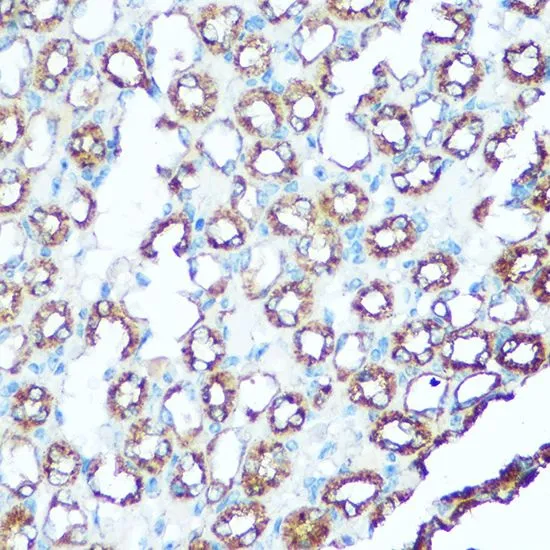

IHC-P analysis of human colon tissue using GTX33572 UQCRC1 antibody. Dilution : 1:100
UQCRC1 antibody
GTX33572
ApplicationsWestern Blot, ImmunoHistoChemistry, ImmunoHistoChemistry Paraffin
Product group Antibodies
ReactivityHuman, Monkey, Mouse, Rat
TargetUQCRC1
Overview
- SupplierGeneTex
- Product NameUQCRC1 antibody
- Delivery Days Customer9
- Application Supplier NoteWB: 1:500 - 1:2000. IHC-P: 1:50 - 1:200. *Optimal dilutions/concentrations should be determined by the researcher.Not tested in other applications.
- ApplicationsWestern Blot, ImmunoHistoChemistry, ImmunoHistoChemistry Paraffin
- CertificationResearch Use Only
- ClonalityPolyclonal
- ConjugateUnconjugated
- Gene ID7384
- Target nameUQCRC1
- Target descriptionubiquinol-cytochrome c reductase core protein 1
- Target synonymsD3S3191, PKNPY, QCR1, UQCR1, cytochrome b-c1 complex subunit 1, mitochondrial, complex III subunit 1, core protein I, ubiquinol-cytochrome c reductase core protein I, ubiquinol-cytochrome-c reductase complex core protein 1
- HostRabbit
- IsotypeIgG
- Protein IDP31930
- Protein NameCytochrome b-c1 complex subunit 1, mitochondrial
- ReactivityHuman, Monkey, Mouse, Rat
- Storage Instruction-20°C or -80°C,2°C to 8°C
- UNSPSC41116161

![UQCRC1 antibody [N1N3] detects UQCRC1 protein at mitochondria on mouse liver by immunohistochemical analysis. Sample: Paraffin-embedded mouse liver. UQCRC1 antibody [N1N3] (GTX101862) diluted at 1:500.
Antigen Retrieval: Trilogy? (EDTA based, pH 8.0) buffer, 15min](https://www.genetex.com/upload/website/prouct_img/normal/GTX101862/GTX101862_39568_20141205_IHC_M_w_23060100_525.webp)



![HepG2 and mitochondria extracts (30 μg) were separated by SDS-PAGE, and the membrane was blotted with UQCRC1 antibody [GT1311] (GTX630393) diluted at 1:1000. The HRP-conjugated anti-mouse IgG antibody (GTX213111-01) was used to detect the primary antibody.](https://www.genetex.com/upload/website/prouct_img/normal/GTX630393/GTX630393_41526_20191129_WB_Fraction_w_23061202_131.webp)
![UQCRC1 antibody [GT139] detects UQCRC1 protein by western blot analysis. A. 50 μg mouse brain lysate/extract 7.5 % SDS-PAGE UQCRC1 antibody [GT139] (GTX630413) dilution: 1:1000](https://www.genetex.com/upload/website/prouct_img/normal/GTX630413/GTX630413_41540_WB_M_brain_w_23061202_363.webp)